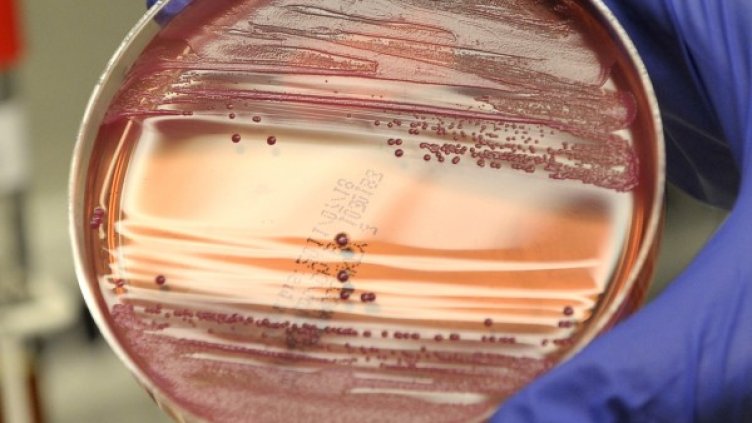
Снимка: архив, Reuters

Непознат вид бактерия беше открит в стерилни помещения на НАСА, където строят космическите апарати, съобщи в. "Дейли телеграф".
Тези помещения се поддържат изключително сухи, чистят ги с химикали, включително и белина, а налягането на въздуха е отрицателно именно за да са неблагоприятни за всякакви форми на живот. Влизащите в тях носят специално облекло, всичко се обработва с ултравиолетова светлина и топлина.
НАСА обаче откри там издръжлива непозната бактерия, която може да живее в толкова враждебна среда. Тя е намерена в две отделни стерилни помещения - едното във Флорида, където беше построен марсианският спускаем космически апарат "Феникс", а другото в Куро, Френска Гвиана, където има база на Европейската космическа агенция.
Бактерията Tersicoccus phoenicis e толкова необичайна, че е класифицирана не само като нов вид, но и като нов род. Тя е с размер 1 микрометър.
"Тази бактерия живее почти без храна - каза Параг Ваишампаян, микробиолог от Лабораторията за реактивни двигатели на НАСА. - Искаме да изучим по-добре тези организми, защото със способността си да живеят в стерилни помещения може да оцелеят и на космически апарат. Същите бактерии може да живеят в пръстта пред сградата със стерилното помещение, но там не ги откриваме, защото има толкова много други организми".
(БТА)

Иранските ракетни арсенали чакат под земята да бъдат отново изровени
Иранските ракетни арсенали чакат под земята да бъдат отново изровени  Дроновете на Украйна предефинират военната стратегия на Германия
Дроновете на Украйна предефинират военната стратегия на Германия  Великобритания търси как да привлече 1 млн. младежи, които нито учат, нито работят
Великобритания търси как да привлече 1 млн. младежи, които нито учат, нито работят  Дипломатите на Доналд Тръмп не са единствената опция за преговорите за мир
Дипломатите на Доналд Тръмп не са единствената опция за преговорите за мир  Съюзниците предупредиха САЩ - разделението ограничава възпиращата сила
Съюзниците предупредиха САЩ - разделението ограничава възпиращата сила  Сделки с Иран за преминаване на Ормузкия проток са забранени за американски граждани
Сделки с Иран за преминаване на Ормузкия проток са забранени за американски граждани 
 Зеленски очаква пратениците на Тръмп в Украйна за преговори след две седмици
Зеленски очаква пратениците на Тръмп в Украйна за преговори след две седмици  Няколко зодии ще излекуват дълбока емоционална травма през юни
Няколко зодии ще излекуват дълбока емоционална травма през юни  Украйна пречупи Полша с 2:0 във Вроцлав
Украйна пречупи Полша с 2:0 във Вроцлав  Камен Кенов: Българинът е бил здрав селяк и непобедим войник
Камен Кенов: Българинът е бил здрав селяк и непобедим войник  Франция свиква Съвета за сигурност на ООН заради Ливан
Франция свиква Съвета за сигурност на ООН заради Ливан  Домашен шоколадов сладолед с ликьор
Домашен шоколадов сладолед с ликьор 
 Йонас Вингегор спечели Джирото
Йонас Вингегор спечели Джирото  ЦСКА цака Левски за огромна звезда от България
ЦСКА цака Левски за огромна звезда от България  Христо Янев обяви грандиозна новина за селекцията на ЦСКА
Христо Янев обяви грандиозна новина за селекцията на ЦСКА  Артета бесен на съдията и заяви: Боли ни...
Артета бесен на съдията и заяви: Боли ни...  Левски се подсилва с камерунски защитник?
Левски се подсилва с камерунски защитник?  Гръм и мълнии в Уругвай! Луис Суарес не е в състава за световното!
Гръм и мълнии в Уругвай! Луис Суарес не е в състава за световното! 
 Дневен хороскоп за 1 юни, понеделник
Дневен хороскоп за 1 юни, понеделник  Седмичен хороскоп за 1 - 7 юни: Меркурий преминава в Рак
Седмичен хороскоп за 1 - 7 юни: Меркурий преминава в Рак  33 вдъхновяващи мисли от велики детски книги за Деня на детето
33 вдъхновяващи мисли от велики детски книги за Деня на детето  Ритуали за пречистване за всяка зодия през юни
Ритуали за пречистване за всяка зодия през юни  Месечен хороскоп за юни 2026
Месечен хороскоп за юни 2026  Нумерологична прогноза за 31 май
Нумерологична прогноза за 31 май 
 продава, Къща, 117 m2 Добрич област, гр.Балчик, 177000 EUR
продава, Къща, 117 m2 Добрич област, гр.Балчик, 177000 EUR  продава, Заведение, 510 m2 Смолян област, гр.Девин (Настан), 765000 EUR
продава, Заведение, 510 m2 Смолян област, гр.Девин (Настан), 765000 EUR  продава, Тристаен апартамент, 87 m2 Русе, Широк Център, 167000 EUR
продава, Тристаен апартамент, 87 m2 Русе, Широк Център, 167000 EUR  продава, Гараж, паркомясто, 16 m2 Русе, Идеален Център, 16500 EUR
продава, Гараж, паркомясто, 16 m2 Русе, Идеален Център, 16500 EUR  продава, Двустаен апартамент, 131 m2 София, Банкя (гр.), 157118 EUR
продава, Двустаен апартамент, 131 m2 София, Банкя (гр.), 157118 EUR  продава, Земеделски имот, 5314 m2 Смолян област, гр.Девин (Настан), 42520 EUR
продава, Земеделски имот, 5314 m2 Смолян област, гр.Девин (Настан), 42520 EUR 
 Доверието към Радев е като към наета фирма - интересът към "работниците" е вторичен
Доверието към Радев е като към наета фирма - интересът към "работниците" е вторичен  Какво представлява "швейцарското правило", по което от 1 юли ще бъдат осъвременени пенсиите
Какво представлява "швейцарското правило", по което от 1 юли ще бъдат осъвременени пенсиите  Български град е сред най-древните в света
Български град е сред най-древните в света  Българи с имоти в Гърция могат да получат до 36 000 евро за ремонт по нова държавна програма
Българи с имоти в Гърция могат да получат до 36 000 евро за ремонт по нова държавна програма  Изненадващо проучване: най-зеленомислещите богати замърсяват най-много
Изненадващо проучване: най-зеленомислещите богати замърсяват най-много  Селата в България без нито един жител са 199
Селата в България без нито един жител са 199 
 Стивън Спилбърг: Възможно е извънземни вече да са били на Земята
Стивън Спилбърг: Възможно е извънземни вече да са били на Земята  Разкрити са тайните дневници на бащата на Стивън Хокинг
Разкрити са тайните дневници на бащата на Стивън Хокинг  Испания и ЕС представиха нов квантов суперкомпютър на стойност 10 млн. евро
Испания и ЕС представиха нов квантов суперкомпютър на стойност 10 млн. евро  Поколението Z и AI: Кои професии са защитени от изчезване
Поколението Z и AI: Кои професии са защитени от изчезване  Каква ще бъде слънчевата активност през уикенда (30-31 май)
Каква ще бъде слънчевата активност през уикенда (30-31 май)  НАСА стартира нов проект за отглеждане на стволови клетки на борда на МКС
НАСА стартира нов проект за отглеждане на стволови клетки на борда на МКС 










